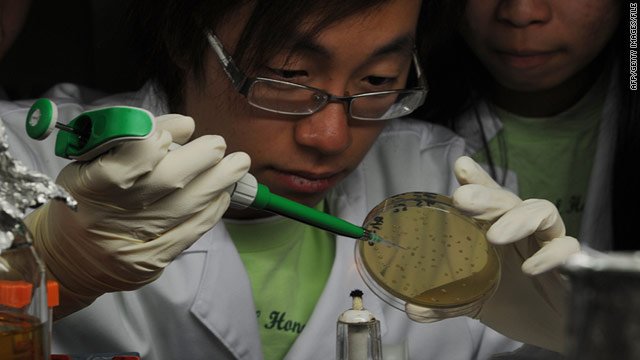
Dünyada en çok bilimsel makale üreten ülke Çin oldu

ABD Ulusal Bilim Vakfı’nın (NSF) derlediği istatistiklere göre, Çin, bilimsel yayın konusunda ABD’yi solladı. Kuruluşun 18 Ocak’ta yayınladığı rapor, Amerika Birleşik Devletleri ile Çin ve diğer bilim ve teknolojiye yatırımlarını artıran gelişmekte olan ülkeler arasındaki rekabetin yükseldiğini belgeliyor. Bununla beraber, raporda Amerika’nın üst düzey bilimsel araştırmalar yürüterek, yabancı öğrencileri çekerek ve bilimi değerli fikir hakkına dönüştürerek etkin bir güç olmaya devam ettiği ifade ediliyor.
“ABD bilim ve teknolojide dünya lideri olmaya devam ediyor, ancak dünya değişiyor.” diyor Cambridge’teki Massachusetts Teknoloji Enstitüsü’nden jeofizikçi Maria Zuber. NSF’yi denetleyen Ulusal Bilim Kurulu başkanı ve raporu hazırlayan Zuber, “Diğer uluslar faaliyetlerini artırdıkça Amerika Birleşik Devletleri’nin küresel bilim etkinliği alanındaki payı azalıyor. Görevimiz başında uyuyamayız.” diye ekliyor.
Değişen durum, yayınların sayısından da açıkça belli oluyor: Çin 2016 yılında 426.000 çalışma yayınladı; bu rakam Elsevier’s Scope veritabanındaki toplam yayınların %18,6’sına denk geliyor. Amerika Birleşik Devletleri’nde yayınlanan makale sayısı ise yaklaşık 409.000. Hindistan ise Japonya’yı geçti ve gelişen dünyanın geri kalanı da yükselişine devam etti.
Ancak, araştırmacılar, en çok alıntılanan yayınların nerede yazılmış olduğuna baktıklarında farklı bir tablo gördüler. Rapora göre Amerika, İsveç ve İsviçre’nin gerisinde kalarak üçüncü, Avrupa Birliği dördüncü ve Çin beşinci sırada yer alıyor.
ABD hala bilim ve teknoloji alanında en çok doktora mezunu veren ülke ve yüksek lisans yapmak isteyen uluslararası öğrenciler için birinci tercih konumunda. Ancak bu öğrencilerin oranı 2000 yılında %25 iken 2014 yılında %19’a geriledi.
Amerika, 2015 yılında, dünya toplamının %26’sına denk gelen 500 milyar dolarla, araştırma-geliştirme (Ar- Ge) alanında en çok harcama yapan ülke oldu. Çin, yaklaşık 400 milyar dolarla ikinci sıraya oturdu. Ancak son yıllarda Çin, Ar-Ge harcamalarını ülke ekonomisine oranla artırırken, Amerika’da bu oran aynı kaldı.
NSF’nin iki yılda bir çıkan dergisi Science and Engineering Indicators’ın son sayısında yer alan analiz, ABD’de bilimin durumu hakkındaki endişelerin arttığı bir zamana denk geldi. “Bu, bazı tehlikelere dikkat çekiyor.” diyor Washington D.C.’deki bir düşünce kuruluşu olan Brooking Enstitüsü’nden akademisyen Muro ve ekliyor: “Amerika’daki bilim harcamaları eğilimleri yanlış yönde ilerliyor ve araştırmacıların yetenek havuzu, kadınların ve azınlıkların yeterince temsil edilmemesi nedeniyle kısıtlı kalmaya devam ediyor.”
NSF ilk kez istatistiksel analizlerine teknoloji transferi ve buluş bölümünü ekledi. Veriler, Amerika’nın patent, fikir hakkı geliri ve yeni teknolojiler alanında girişim gibi konularda dünyaya liderlik etmeye devam ettiğini gösteriyor. Muro’ya göre yerel ve bölgesel düzeyde daha çok odaklanma gerekse de, rapor, bilimsel yenilenmenin önemini gözler önüne seriyor.
Muro, “Bir ülkenin yenilik kapasitesi, o ülkenin verimliliğini artıran, dolayısıyla da refahı sağlayan en önemli dinamiklerden biridir” diyor ve ekliyor: “Yeni veriler bu göstergelere en başında neden güvendiğimizi hatırlatıyor.”
Kaynak: https://www.nature.com/articles/d41586-018-00927-4
Çeviri: Defne DURU